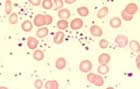

Kurzbeschreibung:
Die essentielle Thrombozythämie gehört zu den myeloproliferativen Neoplasien (MPN), betrifft fast ausschliesslich die megakaryozytäre Linie und ist charakterisiert durch eine anhaltende Erhöhung der Thrombozyten >450 x109/L. Die Werte können weit über 1000 x 109/L ansteigen. Symtome sind venöse und arterielle Thrombosen sowie Blutungskomplikationen. In ca. 60% der Fälle kann eine JAK2 V617F-Muatation, in 25% eine Mutation im Gen Calretikulin (CALR) und in 2% eine Mutation im Thrombopoietinrezeptor MPL nachgewiesen werden.
Klinisches Bild:
Es handelt sich um eine Krankheit des älteren Menschen mit einem Durchschnittsalter um 60 Jahre. Die Inzidenz beträgt ca. 1.0/100'000/Jahr. Oft sind die Patienten beschwerdefrei. Bei >50% der Fälle wird die Diagnose per Zufall gestellt. Symptome entstehen durch Störung der Mikrozirkulation sowie durch venöse und arterielle Thrombosen. Dazu gehören wechselnde neurologische Beschwerden wie Kopfschmerzen, Schwindel und brennenden Fusssohlen (Erythromelalgia), periphere arterielle Verschlusskrankheit, ischämische Hirninfarkte und Myokardinfarkte sowie venöse Thrombosen der Lebervenen (Budd-Chiari-Syndrom) und des Portalkreislaufs. Wichtig ist die differentialdiagnostische Abgrenzung von den vielen Ursachen einer sekundären Thrombozytose, die nicht mit thrombotischen Komplikationen assoziiert sind.
Pathomechanismus:
JAK2 V617F, MPL-Mutation und CALR-Mutationen sind sogenannte "Driver"-Mutationen, die direkt den Phänotyp einer gesteigerten Megakaryopoiese herbeiführen. Der Thrombopoietinrezeptor MPL und JAK2 sind dabei Teil des wichtigen Signalweges, der die Megakaryopoiese antreibt. Der genaue Funktionsmechanismus der CALR-Muatationen ist noch unklar. Es wird heute davon ausgegangen, dass mindestens in einem Teil der Patienten weitere Mutationen notwendig sind, um die Krankheit auszulösen. Noch ungenügend wird verstanden, weshalb die gleichen Mutationen unterschiedliche Krankheitsbilder (PMF, ET oder PV) hervorrufen können.
Therapie:
Um thrombotische Komplikationen zu vermeiden, müssen die Thrombozyten reduziert werden. Dabei kommen Hydroxyurea (Litalir®), Anagrelid (Xagrid®, Thromboreductin®) und Interferon-alpha zum Einsatz.
Hämatologie:
Die Thrombozyten betragen >450 x109/L, können aber auch Werte weit über 1000 x 109/L erreichen. Das mittlere Thrombozytenvolumen ist oft vergrössert, mit Thrombozytenanisozytose und Riesenplättchen sowie hypo- oder agranulären Formen. Gelegentlich finden sich Megakaryozytenkernreste. Eine Basophilie ist typisch, aber kaum sehr ausgeprägt. Eine milde Leukozytose bis maximal 20 x109/L kann vorkommen, höhere Werte sprechen gegen die Diagnose einer ET.
Knochenmark:

Die
Diagnose:
Gemäss der WHO 2008-Klassifikation kann eine essentielle Thrombozythämie diagnostiziert werden, falls folgende vier Kriterien erfüllt sind: